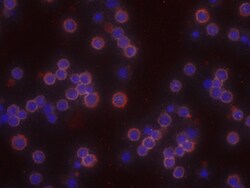
Human CD28 Antibody, R D Systems 200 &mu;g | Buy Online | R&D Systems | Fisher Scientific

missing translation for 'onlineSavingsMsg'
Learn More
Learn More
Human CD28 Antibody, R&D Systems™


Description
CD28 Polyclonal specifically detects CD28 in Human samples. It is validated for Flow Cytometry, Immunohistochemistry, Agonist Activity, Immunocytochemistry, CyTOF-ready.

Spécification
Spécification
| Antigène | CD28 |
| Applications | Western Blot, Flow Cytometry, Agonist Activity, Immunocytochemistry, CyTOF |
| Classification | Polyclonal |
| Concentration | LYOPH |
| Conjugué | Unconjugated |
| Dilution | Western Blot 0.1 ug/mL, Flow Cytometry 2.5 ug/10^6 cells, Agonist Activity 0.3-0.6 ug/mL, Immunocytochemistry 5-15 ug/mL, CyTOF-ready |
| Numéro d’ordre du gène | P10747 |
| Alias de gène | CD28, CD28 antigen, CD28 antigen (Tp44), CD28 molecule, MGC138290, T-cell-specific surface glycoprotein CD28, Tp44 |
| Symboles de gène(s) | CD28 |
| Espèces hôtes | Goat |
| Afficher plus |
Nom du produit
En cliquant sur Soumettre, vous reconnaissez que vous pouvez être contacté par Fisher Scientific au sujet des informations que vous avez fournies dans ce formulaire. Nous ne partagerons pas vos informations à d'autres fins. Toutes les informations de contact fournies seront également conservées conformément à notre politique de confidentialité. Politique de confidentialité.
Vous avez repéré une opportunité d'amélioration ?